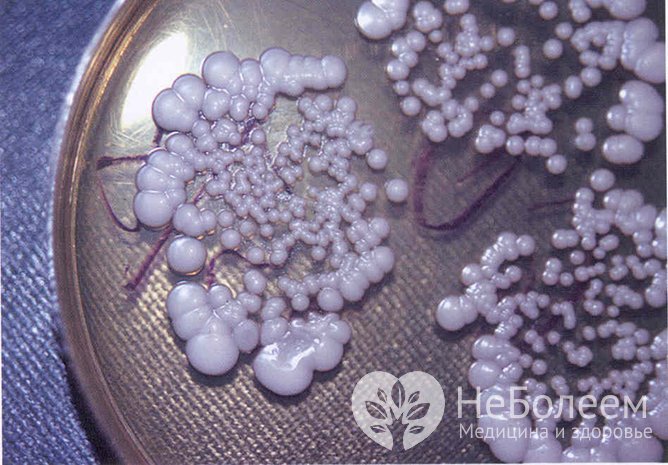
Грибы Candida приводят к развитию патологии обычно на фоне сниженного местного иммунитета

Воспользуйтесь поиском по сайту:
Тонзиллит: симптомы, причины, лечение
Содержание статьи:
Тонзиллит – часто встречаемое заболевание. Наиболее ему подвержены дети (примерно 60–65% всех острых респираторных инфекций), особенно часто – в возрасте 5–10 лет. Симптомы патологии у взрослых и детей зависят от течения воспалительного процесса, наличия сопутствующих заболеваний.
 Тонзиллит характеризуется воспалением небных миндалин
Тонзиллит характеризуется воспалением небных миндалинЧто такое тонзиллит? Тонзиллит (от лат. tonsillae – миндалины) – это инфекционное заболевание, ведущим признаком которого является острый или хронический воспалительный процесс в небных миндалинах.
Хроническое воспаление часто способствует развитию различных осложнений. Острый тонзиллит, или ангина является распространенным заболеванием, для которого характерны подъемы заболеваемости в весенний и осенний период. У взрослых патология встречается в 5–20% случаев острых респираторных инфекций.
Причины тонзиллита
Болезнь развивается при попадании в организм патогенных бактерий или вирусов. Наиболее частыми возбудителями среди вирусов являются:
- аденовирус;
- вирус парагриппа;
- респираторно-синцитиальный вирус;
- риновирус;
- энтеровирусы;
- вирус Эпштейна – Барр.
 Пиогенный стрептококк – один из наиболее частых возбудителей болезни среди бактерий
Пиогенный стрептококк – один из наиболее частых возбудителей болезни среди бактерийСреди бактериальных возбудителей важную роль играет бета-гемолитический стрептококк группы А, или пиогенный стрептококк. С ним связано около 15% случаев ангин. Стрептококк передается воздушно-капельным, контактным и пищевым путем.
Также заболевание могут вызывать:
- стрептококки групп С и G;
- пневмококки;
- анаэробы;
- микоплазмы;
- хламидии;
- спирохеты;
- гонококки.
Возбудитель попадает в слизистую оболочку миндалин экзогенным путем с вдыхаемым воздухом или с пищей, а также эндогенным путем – из хронических очагов инфекций либо при повышении патогенности сапрофитной микрофлоры на фоне снижения общего или местного иммунитета.
Грибы Candida приводят к развитию патологии обычно на фоне сниженного местного иммунитета
Грибы Candida приводят к развитию патологии обычно на фоне сниженного местного иммунитетаВ условиях местного иммунодефицита возбудителем могут быть дрожжеподобные грибы рода Candida, которые входят в нормальную флору ротоглотки.
Развитию воспалительного процесса способствуют:
- травма миндалин;
- хронические воспалительные заболевания полости рта, носа и придаточных пазух;
- нарушение носового дыхания;
- сопутствующие соматические заболевания разных органов и систем, которые влияют на общую реактивность организма.
Морфологически при воспалении миндалин в паренхиме происходит расширение кровеносных и лимфатических сосудов, инфильтрация слизистой оболочки лейкоцитами.
В патогенезе хронического воспаления основную роль играет нарушение защитно-приспособительных механизмов миндалин, сенсибилизация организма. Имеющаяся в лакунах патогенная микрофлора при хронической ангине может стать пусковым фактором в развитии аутоиммунных процессов.
Классификация
Код тонзиллита по МКБ-10 (Международной классификации болезней 10 пересмотра):
- J03.0 – стрептококковый;
- J03.8 – острый, вызванный другими уточненными возбудителями;
- J03.9 – острый неуточненный;
- J35.0 – хронический.
Тонзиллит в зависимости от течения воспаления делится на острый и хронический. Острый, в свою очередь, может быть первичным или вторичным.
Первичный острый тонзиллит имеет следующие формы:
- катаральная;
- лакунарная;
- фолликулярная;
- язвенно-пленчатая, или некротическая.
 У детей вторичный острый тонзиллит часто возникает при скарлатине
У детей вторичный острый тонзиллит часто возникает при скарлатинеВторичный острый тонзиллит может возникнуть при острых инфекционных заболеваниях, таких как:
Также вторичный воспалительный процесс развивается на фоне гематологических заболеваний (при агранулоцитозе, лейкозах, алиментарно-токсической алейкии).
Хронические тонзиллиты подразделяют на неспецифические и специфические. Неспецифический хронический тонзиллит имеет компенсированную и декомпенсированную форму. Специфическое воспаление миндалин развивается при инфекционных гранулемах – туберкулезе, сифилисе, склероме.
Также существует клиническая классификация форм патологии:
- катаральная;
- фолликулярная;
- лакунарная;
- некротическая;
- флегмонозная;
- фибринозная;
- герпетическая;
- смешанная.
Читайте также:9 способов борьбы с депрессией без лекарств
Симптомы тонзиллита
Основными признаками тонзиллита являются:
- дискомфорт или боль в горле, усиливающаяся при глотании, возможна иррадиация боли в ухо;
- повышение температуры тела (тонзиллит может протекать и без температуры);
- гнилостный запах изо рта;
- сухой кашель;
- ухудшение самочувствия: общая слабость, боли в мышцах и суставах, головные боли, снижение работоспособности.
При лакунарной форме происходит скопление в лакунах серозно-слизистого и гнойного отделяемого. Гной состоит из лейкоцитов, лимфоцитов, эпителия и фибрина. Могут образоваться широкие сливные налеты.
При возникновении сильного отека миндалин может появляться чувство сдавленности в шее, затруднение дыхания.
Диагностика
Для того чтобы установить диагноз и провести дифференциальную диагностику, необходимо:
- сбор жалоб и анамнеза;
- осмотр;
- инструментальное обследование, включающее фарингоскопию;
- микроскопическое, цитологическое, бактериологическое исследование отделяемого со слизистой оболочки миндалин, ротоглотки;
- клинический анализ крови.
По фото горла, сделанным во время фарингоскопии, наглядно видны изменения при ангине. Существует несколько видов фарингоскопии, которые позволяют визуально осмотреть ротоглотку и оценить состояние слизистой оболочки.
 Фарингоскопия позволяет определить изменения небных миндалин
Фарингоскопия позволяет определить изменения небных миндалинПри катаральной форме отмечается гиперемия миндалин, они выглядят набухшими, эпителий разрыхлен и пропитан серозным секретом. Гнойных налетов нет.
Для фолликулярной формы характерно просвечивание фолликулов через слизистую оболочку в виде желтых точек.
При лакунарной форме происходит скопление в лакунах серозно-слизистого и гнойного отделяемого. Гной состоит из лейкоцитов, лимфоцитов, эпителия и фибрина. Могут образоваться широкие сливные налеты.
Для флегмонозной формы характерно нарушение дренажа лакун, отек паренхимы миндалин, некротические изменения в фолликулах, которые, сливаясь, могут образовать абсцесс. Такой гнойник располагается близко к поверхности миндалины и опорожняется в ротовую полость.
Для кандидозной ангины характерна умеренная гиперемия миндалин, наличие творожистого налета белого или желтого цвета. Как правило, грибковому поражению предшествует длительная антибиотикотерапия.
Заболевание характеризуется увеличением, уплотнением и болезненностью регионарных лимфоузлов: подчелюстных, передних и задних шейных.
При осмотре полости рта или во время фарингоскопии врач проводит забор материала с поверхности миндалин, задней стенки глотки для бактериологического посева с последующим определением чувствительности к антибактериальным препаратам.
Существует экспресс-тест для определения наличия бета-гемолитического стрептококка группы А в соскобе со слизистой оболочки ротоглотки. Выполняется он в течение 5–15 минут и представляет собой иммунохроматографический метод экспресс-диагностики качественной оценки наличия антигена бета-гемолитического стрептококка группы А. Анализ выполняется врачом и не требует специальной лаборатории. Чувствительность теста составляет 97%.
 При необходимости уточнения диагноза назначается клинический анализ крови
При необходимости уточнения диагноза назначается клинический анализ кровиПо клиническому анализу крови оценивают лейкоцитарные сдвиги. Помимо общих изменений в виде повышения количества лейкоцитов и ускорения СОЭ (скорости оседания эритроцитов) при бактериологическом поражении увеличивается число нейтрофилов, появляется большое количество палочкоядерных (юных) лейкоцитов. При вирусном поражении повышаются лимфоциты. Таким образом, анализ помогает в диагностике и дифференциальной диагностике. Например, при инфекционном мононуклеозе увеличивается число моноцитов.
Дифференциальная диагностика
Фолликулярную ангину необходимо дифференцировать с дифтерией ротоглотки. Оба заболевания протекают с высокой температурой и интоксикацией, болями в горле, гиперемией и увеличением миндалин, но есть отличительные признаки, которые помогают врачу правильно поставить диагноз.
 Дифференциальную диагностику проводит ЛОР-врач
Дифференциальную диагностику проводит ЛОР-врачПри фолликулярной ангине желтый налет на миндалинах легко снимается, и кровоточивость при этом не отмечается. При дифтерии образуются островки блестящей, плотной фибринозной пленки, которая снимается с трудом, после чего остается кровоточащая поверхность.
Также при фолликулярной ангине рельеф лакун хорошо просматривается, отек миндалин не отмечается, регионарные лимфатические узлы болезненны при пальпации. При дифтерии ротоглотки рельеф миндалин сглажен, они отечны, регионарные лимфоузлы безболезненны.
Для кандидозной ангины характерна умеренная гиперемия миндалин, наличие творожистого налета белого или желтого цвета. Как правило, грибковому поражению предшествует длительная антибиотикотерапия.
При туберкулезе на небных дужках, миндалинах могут образоваться язвы бледно-розового цвета с неровными краями, покрытые гнойным налетом. Правильный диагноз устанавливается благодаря микроскопическому и бактериологическому анализу.
Под видом ангины может протекать опухолевое поражение миндалин, ротоглотки, что проявляется в виде распада ткани. Диагноз устанавливается на основании результатов гистологического исследования биоптата миндалин.
Развитие вторичной ангины возможно при заболеваниях крови, например при остром лейкозе. Фолликулы могут сливаться и распадаться. Для болезни характерно быстрое распространение некротических изменений в миндалинах. В установлении диагноза важную роль играют типичные изменения крови, характерные для лейкоза.
Лечение
При бактериальном поражении назначается системная антибактериальная терапия. Ее целью является уничтожение возбудителя, ограничение очага инфекции, профилактика гнойных и аутоиммунных осложнений. Сначала назначаются препараты группы пенициллинов или цефалоспоринов III поколения. Средствами выбора для лечения острого стрептококкового тонзиллита являются феноксиметилпенициллин, аминопенициллины. Антибиотик назначается на 10 дней.
 Медикаментозная терапия назначается врачом в зависимости от возбудителя болезни, общего состояния и возраста пациента
Медикаментозная терапия назначается врачом в зависимости от возбудителя болезни, общего состояния и возраста пациентаВ случае наличия аллергических реакций на пенициллины (Амоксициллин) и цефалоспорины (Цефиксим) назначаются макролиды. Длительность лечения препаратом Азитромицин составляет 5 дней.
При хронической ангине антибиотики применяются в период обострения.
При отсутствии положительной динамики (в виде снижения температуры тела и уменьшения выраженности болей в горле в течение 72 часов от начала терапии) врач может сменить антибиотик.
Самостоятельно подбирать или заменять препарат не следует, так как это может привести не только к осложнениям, но и способствовать формированию резистентности микроорганизмов к антибиотику. При возникновении побочных реакций необходимо немедленно обратиться к врачу.
При вирусном поражении профилактический прием антибиотиков не рекомендуется.
При кандидозной форме проводится системная противогрибковая терапия.
Для снижения температуры тела и уменьшения болей показано симптоматическое лечение нестероидными противовоспалительными средствами (Парацетамол, Ибупрофен).
 В составе комплексного лечения показано проведение ингаляций и полосканий
В составе комплексного лечения показано проведение ингаляций и полосканийОчень важно проводить местное лечение в виде полосканий, ингаляций, применения таблеток и пастилок для рассасывания. Благодаря этому уменьшается выраженность болевого синдрома. Она не исключает системную антибиотикотерапию.
Рекомендуются местные антисептики:
- хлоргексидин;
- препараты йода;
- сульфаниламиды;
- биклотимол;
- лизоцим.
Миндалины смазывают 1% раствором Люголя, 2% раствором колларгола, 40% раствором прополиса или интерфероновой мазью.
При бактериальном поражении назначается системная антибактериальная терапия. Ее целью является уничтожение возбудителя, ограничение очага инфекции, профилактика гнойных и аутоиммунных осложнений.
После промывания внутрилакунарно вводят антисептические пасты: этониевую, грамицидиновую. Они обладают широким спектром воздействия, оказывая бактериостатическое действие на патогенную микрофлору.
По показаниям назначаются общеукрепляющие и иммуностимулирующие средства.
При хронической ангине дополнительно проводится физиотерапевтическое лечение.
Профилактика
Профилактические меры по предупреждению развития ангины включают:
- соблюдение правил личной гигиены;
- прием комплексных витаминных препаратов в осенний и весенний период;
- ограничение контактов с больными острым тонзиллитом для профилактики воздушно-капельного пути передачи инфекции;
- лечение хронических инфекций верхних дыхательных путей.
Осложнения
Чем опасен воспалительный процесс в миндалинах? Ангина может вызывать тяжелые осложнения, приводить к заболеваниям сердечно-сосудистой системы.
 Отит – одно из возможных осложнений тонзиллита
Отит – одно из возможных осложнений тонзиллитаПри несвоевременной диагностике или неадекватном лечении возможен переход острого процесса в хронический.
Стрептококковая ангина может вызвать гнойные осложнения:
- отит;
- синусит;
- мастоидит;
- паратонзиллярный абсцесс;
- шейный лимфаденит;
- менингит;
- эндокардит;
- пневмония.
Также возможны поздние негнойные последствия:
- постстрептококковый гломерулонефрит;
- токсический шок;
- острая ревматическая лихорадка.
Видео
Предлагаем к просмотру видеоролик по теме статьи.
Об авторе

Опыт работы: 4 года работы в частной практике.
Информация является обобщенной и предоставляется в ознакомительных целях. При первых признаках болезни обратитесь к врачу. Самолечение опасно для здоровья!
На лекарства от аллергии только в США тратится более 500 млн долларов в год. Вы все еще верите в то, что способ окончательно победить аллергию будет найден?
























